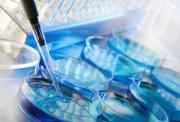
Image of petri dish in laboratory

Our research successes
With the help of our supporters we have played a significant role in many medical breakthroughs, starting with the development of the first polio vaccines in the UK, later helping to develop the use of ultrasound in pregnancy and test the rubella vaccine – helping to save thousands of children’s lives and change many more.